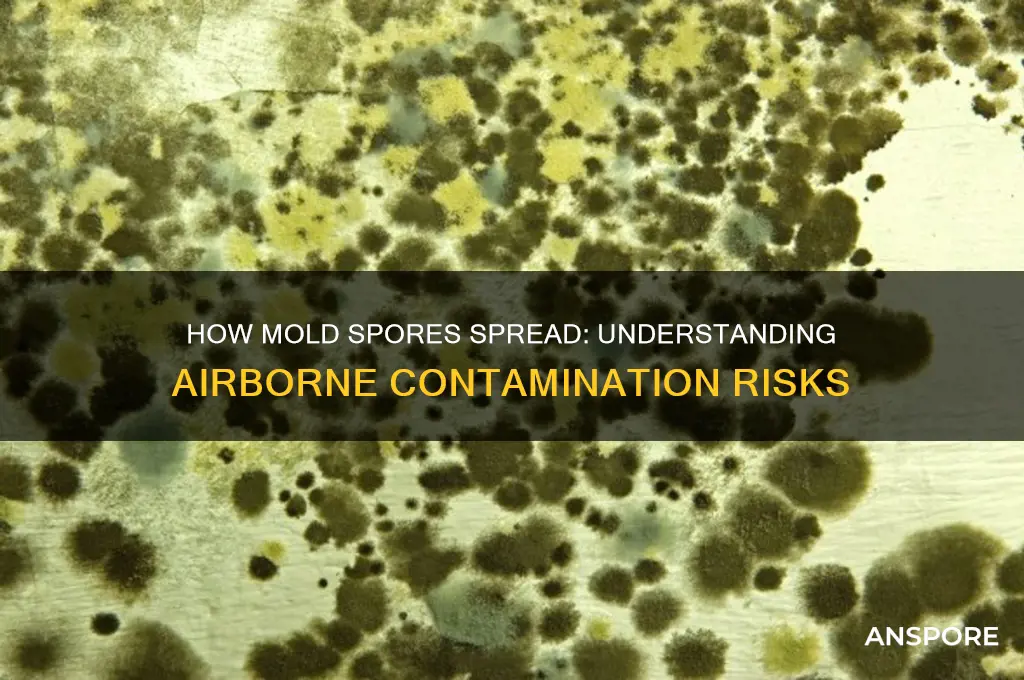
do mold spores spread

Mold spores are microscopic, lightweight, and ubiquitous in both indoor and outdoor environments, making their spread a significant concern for homeowners and health professionals alike. These spores travel through the air, on clothing, pets, and even through HVAC systems, easily dispersing from their original source to colonize new areas under favorable conditions—such as dampness, warmth, and organic material. Once airborne, they can remain suspended for extended periods, increasing the likelihood of inhalation or settling on surfaces where they may grow if moisture is present. Understanding how mold spores spread is crucial for preventing infestations and mitigating health risks, as prolonged exposure can lead to respiratory issues, allergies, and other health problems. Effective prevention strategies include controlling humidity levels, promptly addressing water damage, and improving ventilation to discourage spore proliferation.
| Characteristics | Values |
|---|---|
| Spread Mechanism | Mold spores spread primarily through air, water, and physical contact. |
| Airborne Transmission | Spores are lightweight and can travel long distances via air currents, HVAC systems, and open windows. |
| Water Dispersal | Spores can spread through water, especially in humid environments or via flooding. |
| Physical Contact | Spores adhere to clothing, pets, shoes, and other surfaces, facilitating their transfer between locations. |
| Optimal Conditions | Spores thrive and spread in environments with high humidity (above 60%), warmth (25-30°C), and organic matter. |
| Survival Ability | Mold spores can remain dormant for long periods, reactivating when conditions become favorable. |
| Health Impact | Inhaling mold spores can cause allergies, respiratory issues, and infections, especially in immunocompromised individuals. |
| Prevention Measures | Reducing humidity, fixing leaks, proper ventilation, and regular cleaning can prevent spore spread. |
| Detection | Visible mold growth, musty odors, and allergy symptoms indicate potential spore presence. |
| Remediation | Professional removal is recommended for large infestations; small areas can be cleaned with appropriate fungicides. |
Explore related products
$13.48 $14.13
What You'll Learn
- Airborne Transmission: Mold spores travel through air currents, spreading easily indoors and outdoors
- Water Damage Role: Moist environments from leaks or floods accelerate spore growth and dispersal
- Human Activity Impact: Disturbing moldy surfaces releases spores into the air, aiding spread
- HVAC Systems: Heating and cooling systems can circulate mold spores throughout buildings
- Outdoor Sources: Soil, plants, and decaying organic matter are natural spore reservoirs

Airborne Transmission: Mold spores travel through air currents, spreading easily indoors and outdoors
Mold spores are microscopic, lightweight, and ubiquitous, making them masters of airborne transmission. Their size, typically 2-10 microns, allows them to remain suspended in air currents for extended periods, traveling far beyond their original source. This natural dispersal mechanism, essential for mold’s survival and reproduction, poses a significant challenge indoors, where ventilation systems, fans, and even human movement can inadvertently spread spores throughout a building. Outdoors, wind carries spores across vast distances, colonizing new environments with ease. Understanding this airborne nature is crucial for both prevention and remediation efforts.
Consider the mechanics of spore dispersal: when mold grows on damp materials like wood, drywall, or fabric, it releases spores into the air as part of its reproductive cycle. A single square inch of mold can release up to 30,000 spores per hour under optimal conditions. Indoors, these spores can circulate through HVAC systems, settling on surfaces or remaining airborne until they find a suitable environment to grow. For example, a mold-infested basement can contaminate upper floors if spores are drawn into the heating or cooling system. Outdoors, seasonal changes and weather patterns influence spore concentration, with peak levels often occurring in humid, warm conditions.
To mitigate airborne transmission, focus on controlling moisture and improving air quality. Practical steps include fixing leaks promptly, maintaining indoor humidity below 50%, and using dehumidifiers in damp areas. HEPA air purifiers can capture airborne spores, reducing their presence in indoor environments. When cleaning moldy areas, avoid dry brushing or sweeping, as these actions aerosolize spores, increasing airborne concentrations. Instead, use damp cloths and wear an N95 respirator to protect against inhalation. For severe infestations, consult professionals who use containment barriers and negative air pressure to prevent spore spread during remediation.
Comparing indoor and outdoor environments highlights the importance of context-specific strategies. Outdoors, spore spread is largely uncontrollable, but indoors, you have the power to limit their movement. For instance, sealing windows during high-spore seasons (often late summer to early fall) and using air conditioners with filters can reduce indoor exposure. In contrast, outdoor activities like gardening or lawn mowing can stir up spores, so wearing masks during these tasks can be beneficial, especially for individuals with allergies or respiratory conditions.
The takeaway is clear: airborne transmission is a primary pathway for mold spore spread, both indoors and outdoors. By understanding the mechanisms and implementing targeted measures, you can minimize their impact on health and property. Whether through proactive moisture control, strategic air filtration, or informed outdoor practices, addressing airborne spores is a critical step in mold management. Ignoring this aspect risks not only recurrent mold growth but also potential health issues, such as allergic reactions or respiratory problems, particularly in vulnerable populations like children, the elderly, or those with compromised immune systems.
Effective Methods to Remove Mold Spores from Your Clothes Safely
You may want to see also

Water Damage Role: Moist environments from leaks or floods accelerate spore growth and dispersal
Mold spores are opportunistic travelers, and water damage rolls out the welcome mat. When leaks or floods create damp conditions, they transform your home into a mold spore paradise. These microscopic fungi thrive in moisture-rich environments, using it as fuel for rapid growth and reproduction. Imagine a damp basement after a pipe bursts – within 24 to 48 hours, mold colonies can begin to form, releasing millions of spores into the air. This isn't just unsightly; it's a health hazard, especially for those with allergies, asthma, or compromised immune systems.
Understanding the Mechanism:
Water damage disrupts the delicate balance of indoor humidity, typically maintained between 30-50%. When this rises above 60%, mold spores, ever-present in the air, find the perfect conditions to germinate. They latch onto damp surfaces like drywall, carpeting, or wood, feeding on the organic material and multiplying exponentially. The resulting colonies release even more spores, creating a vicious cycle of growth and dispersal.
Think of it like a snowball effect – a small leak, if left unchecked, can lead to a full-blown mold infestation, spreading through the air and contaminating other areas of your home.
The Dangers of Delayed Action:
Time is of the essence when dealing with water damage. The longer moisture persists, the greater the risk of mold growth. Within 24-48 hours, mold can begin to colonize, and within 72 hours, it can spread rapidly, releasing spores into the air and potentially causing structural damage. This is why immediate action is crucial. Promptly addressing leaks, drying affected areas thoroughly, and using dehumidifiers to control humidity levels are essential steps in preventing mold growth.
Remember, mold spores are resilient and can survive in dry conditions, waiting for the next opportunity to thrive.
Practical Prevention and Remediation:
Preventing water damage is the first line of defense against mold. Regularly inspect pipes, roofs, and windows for leaks, and address any issues promptly. In case of flooding, act quickly to remove standing water and dry affected areas within 24-48 hours. Use fans and dehumidifiers to accelerate drying, and consider professional water damage restoration services for severe cases. If mold is already present, wear protective gear (gloves, mask, goggles) and use a solution of bleach and water (1 cup bleach per gallon of water) to clean affected surfaces. For extensive mold growth, consult a professional mold remediation specialist.
Discover the Best Platforms to Play Spore: A Comprehensive Guide
You may want to see also

Human Activity Impact: Disturbing moldy surfaces releases spores into the air, aiding spread
Disturbing moldy surfaces is a common yet often overlooked way humans inadvertently contribute to the spread of mold spores. Whether it’s brushing against a moldy wall, vacuuming a contaminated carpet, or even wiping down a damp countertop, these actions can release millions of spores into the air. Mold spores are lightweight and easily become airborne, traveling through ventilation systems, open windows, or simply settling on nearby surfaces. This process not only accelerates mold growth in new areas but also increases the risk of respiratory issues, allergies, and other health problems for occupants.
Consider the scenario of cleaning a moldy basement. Using a dry cloth or broom to sweep away visible mold may seem efficient, but it’s counterproductive. Each stroke releases spores into the air, creating a cloud that can spread throughout the home. Instead, experts recommend using a damp cloth or a HEPA-filtered vacuum to minimize spore dispersal. For larger infestations, professional remediation is advised, as improper handling can exacerbate the problem. The key takeaway is that mold removal requires careful, informed action to prevent unintended consequences.
From a comparative perspective, disturbing moldy surfaces is akin to stirring a dormant nest of allergens and pathogens. Just as kicking up dust in an attic releases particles into the air, agitating mold disrupts its dormant state, turning it into an active threat. Unlike dust, however, mold spores are biological agents capable of colonizing new areas under the right conditions—moisture, warmth, and organic material. This makes human activity a double-edged sword: while cleaning is necessary, uninformed methods can turn a localized issue into a widespread problem.
To mitigate the impact of human activity on mold spore spread, follow these practical steps: First, assess the extent of mold growth before taking action. Small areas (less than 10 square feet) can often be handled with DIY methods, but larger infestations require professional intervention. Second, use appropriate protective gear, such as N95 masks and gloves, to avoid inhaling spores. Third, isolate the affected area by closing doors and using plastic sheeting to contain the spread. Finally, employ wet cleaning techniques and HEPA-filtered equipment to trap spores rather than dispersing them. By adopting these measures, individuals can address mold issues without becoming agents of its spread.
Mastering Liquid Culture: A Step-by-Step Guide from Spore Syringe
You may want to see also
Explore related products

HVAC Systems: Heating and cooling systems can circulate mold spores throughout buildings
Mold spores are ubiquitous, but their spread indoors often hinges on unseen culprits. HVAC systems, designed to regulate temperature and air quality, can inadvertently become highways for mold distribution. When mold colonizes components like air ducts, coils, or drip pans, the system’s airflow propels spores into every room it services. A single contaminated unit can seed multiple areas, turning a localized issue into a building-wide problem. This silent dissemination underscores why routine HVAC inspections are critical, especially in humid climates where mold thrives.
Consider the mechanics: as air cycles through an HVAC system, it passes over surfaces prone to moisture accumulation. Condensation on evaporator coils or standing water in drain pans creates ideal breeding grounds for mold. Once established, spores detach and mingle with the airstream, traveling through vents into living or working spaces. Studies show that indoor mold spore counts can increase by 50–200% when HVAC systems are compromised, depending on the extent of contamination. This isn’t just a nuisance—it’s a health hazard, particularly for individuals with allergies, asthma, or compromised immune systems.
Preventing HVAC-driven mold spread requires proactive measures. Start by maintaining relative humidity below 60%, as mold growth accelerates in damper conditions. Inspect and clean drip pans monthly, ensuring proper drainage to eliminate standing water. Annually, have ducts and coils professionally cleaned, especially if visible mold is detected. High-efficiency air filters (MERV 11 or higher) can trap spores, but they must be replaced every 1–3 months to remain effective. For existing infestations, hire certified professionals to remediate the system, as DIY attempts often worsen the problem by disturbing spore colonies.
A comparative analysis reveals that modern HVAC designs can mitigate risk. Systems with UV-C light installations, for instance, neutralize mold on coils by disrupting its DNA. Similarly, heat exchangers in newer models reduce condensation, starving mold of moisture. However, these features are no substitute for vigilance. Even advanced systems require regular maintenance, as design flaws or neglect can still foster growth. For example, a 2020 study found that 30% of commercial HVAC systems inspected harbored mold despite having UV lights, due to inadequate cleaning protocols.
The takeaway is clear: HVAC systems are double-edged swords in mold management. While they control environmental factors that suppress mold, they can also accelerate its spread if not managed correctly. Homeowners and facility managers must treat these systems as both a shield and a potential liability. By integrating regular maintenance, humidity control, and advanced technologies, the risk of mold circulation can be minimized. Ignoring this dynamic, however, invites a hidden threat to permeate the very air we breathe.
Exploring Nature's Strategies: How Spores Travel and Disperse Effectively
You may want to see also

Outdoor Sources: Soil, plants, and decaying organic matter are natural spore reservoirs
Mold spores are ubiquitous in the natural environment, and their primary reservoirs are often overlooked yet ever-present: soil, plants, and decaying organic matter. These outdoor sources serve as breeding grounds for mold, continuously releasing spores into the air. For instance, a single square inch of soil can contain thousands of mold spores, which are easily disturbed by wind, foot traffic, or gardening activities. This constant dispersal mechanism ensures that mold spores are not confined to their origin but travel far and wide, settling on surfaces both indoors and out. Understanding this natural cycle is crucial for anyone looking to manage mold exposure, especially in environments where outdoor and indoor spaces intersect.
Consider the role of decaying organic matter, such as fallen leaves, dead trees, or compost piles. These materials are rich in nutrients that mold thrives on, making them ideal spore factories. A pile of wet leaves, for example, can generate millions of mold spores per gram, particularly in damp, warm conditions. Homeowners and gardeners should be mindful of these hotspots, especially during autumn when leaf litter accumulates. Regularly removing or managing decaying vegetation can significantly reduce spore counts in the immediate environment, lowering the risk of mold infiltration into homes through open windows or doors.
Plants, while essential to ecosystems, also contribute to spore dispersal. Mold often colonizes the undersides of leaves, stems, and even flowers, particularly in humid climates. For instance, mold species like *Cladosporium* are commonly found on living plants and can release spores directly into the air. Indoor plants, if overwatered or placed in poorly ventilated areas, can exacerbate this issue, becoming spore reservoirs within the home. To mitigate this, ensure proper spacing between plants, avoid overwatering, and periodically inspect foliage for signs of mold growth. Pruning affected areas and improving air circulation can help keep spore levels in check.
Soil disturbance is another critical factor in spore release. Activities like tilling, digging, or even walking through a garden can kick up spores, making them airborne. Construction sites or landscaping projects that involve soil excavation are particularly prone to this. Workers and nearby residents should take precautions, such as wearing masks rated for particulate matter (e.g., N95) and using water to dampen soil before handling to minimize dust. For those with mold sensitivities or respiratory conditions, monitoring local pollen and mold spore counts (often available through weather forecasts) can help plan outdoor activities during lower-risk periods.
In conclusion, recognizing soil, plants, and decaying organic matter as natural spore reservoirs empowers individuals to take proactive steps in managing mold exposure. By addressing these outdoor sources through practical measures—such as vegetation management, mindful gardening practices, and soil disturbance control—it’s possible to reduce the influx of mold spores into living spaces. This not only improves indoor air quality but also supports overall health, particularly for those vulnerable to mold-related allergies or illnesses. Awareness and action are key to breaking the cycle of spore dispersal from these outdoor reservoirs.
Can Air Purifiers Effectively Remove Mold Spores from Indoor Air?
You may want to see also
Frequently asked questions
Mold spores spread through the air, on surfaces, or via water. They are lightweight and can travel through ventilation systems, open windows, or by attaching to clothing, pets, or objects.
Yes, mold spores can easily spread from one room to another through airflow, HVAC systems, or by being carried on items moved between rooms.
Killing mold does not necessarily stop spores from spreading, as dead mold can still release spores into the air. Proper containment and removal are essential to prevent further spread.































